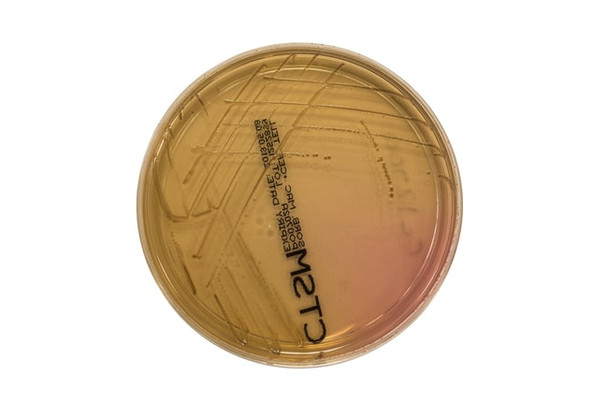
Sorbitol MacConkey Agar with Cefixime Tellurite 90mm Pk 10

Description
fficiently isolate pathogenic Escherichia coli O157:H7 from clinical samples with Thermo Scientific™ Sorbitol MacConkey Agar with Cefixime Tellurite.
Escherichia coli O157:H7 is recognised as a cause of haemorrhagic colitis, an illness characterized by bloody diarrhoea and severe abdominal pain, and haemolytic uraemic syndrome, and, as such, it is a significant human pathogen.
The formulation of Sorbitol MacConkey Agar with Cefixime Tellurite is identical to MacConkey Agar No.3, except that lactose has been replaced with sorbitol. E. coli O157:H7 does not ferment sorbitol and, therefore, produces colorless colonies.
In contrast, most E. coli strains ferment sorbitol and form pink colonies. The addition of cefixime and tellurite significantly reduces the number of sorbitol non-fermenters that need to be screened during the attempted isolation of E. coli O157:H7.